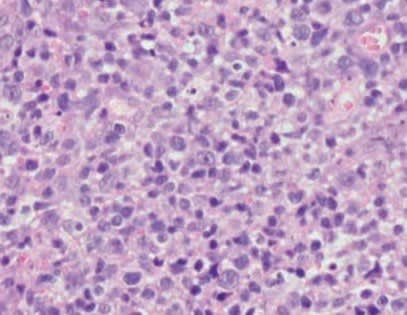
Casos clínicos complejos en dermatología de pequeños animales2

Casos clínicos complejos en dermatología de pequeños animales dermatología de pequeños animales
GRUPO ASIS EDRAServet Edra. 2022. Tapa Dura, 192 páginas. Color, 22 X 28 cms.
Este libro está pensado para todos aquellos veterinarios que sienten pasión por la dermatología. Este fantástico libro, escrito por dos reconocidas especialistas en la materia, explora el proceso del razonamiento diagnóstico en esta especialidad. Se trata de una obra práctica que presenta casos clínicos especialmente complejos, donde las autoras se repasan la presentación clínica, los resultados de las pruebas diagnósticas y las distintas estrategias de tratamiento aplicadas. Incluye además fotos en color, tablas y consideraciones clínicas a tener en cuenta.
Caso 1. Alopecia generalizada asociada a descamación en un perro
Caso 2. Dermatitis ulcerativa extensa en un perro
Caso 3. Dermatosis erosiva y descamativa en un gato
Caso 4. Dermatitis ulcerativa mucocutánea en un perro
Caso 5. Dermatitis ulcerativa multifocal en un perro
Caso 6. Dermatitis pustulosa generalizada en un perro
Caso 7. Dermatitis nodular en un perro
Caso 8. Alopecia generalizada en un gato
Caso 9. Lesiones proliferativas en forma de seudoplacas en un perro
Caso 10. Dermatosis descamativa generalizada en un perro
Caso 11. Placa alopécica, ulcerativa y eritematosa en el tarso de un gato
Caso 12. Alopecia multifocal en un perro
Caso 13. Alopecia no inflamatoria en zonas de pelo negro en dos perros
Caso 14. Dermatitis exfoliativa en un gato
Caso 15. Dermatitis nodular en un perro
Caso 16. Lesiones multifocales, policíclicas y eritematosas asociadas a collarete epidérmico en un perro
Caso 17. Dermatitis erosivo-ulcerativa en un perro con dermatitis atópica estacional
Caso 18. Lesiones ulcerativas mucocutáneas en el plano nasal de un perro
Caso 19. Dermatitis necrotizante en la extremidad de un perro
Caso 20. Dermatitis ulcerativa en un gato
About the Authors
Carla Dedola
La Dra. Carla Dedola es licenciada en Veterinaria por la Universidad de Sácer (Italia) desde el 2001. Tras terminar la carrera, estuvo trabajando en una clínica privada como veterinaria generalista en Monza (Italia). Ahí es donde empezó a interesarte por la dermatología en pequeños animales. En 2007, consiguió plaza para cursar la residencia de dermatología veterinaria en la prestigiosa escuela Royal (Dick) School of Veterinary Studies, en la Universidad de Edimburgo (Escocia). En 2010, aprobó el examen del Colegio Europeo de Dermatología Veterinaria y se convirtió en diplomada europea. Entre 2014 y 2019 ha sido secretaria de la Asociación Italiana de Dermatología en Pequeños Animales (SIDEV). Desde 2011, trabaja como veterinaria autónoma en Cerdeña (Italia), donde colabora con varias clínicas como especialista en dermatología. Asimismo, dirige y es la mentora científica de cursos de dermatología organizados por la Asociación Italiana de Veterinarios especialistas en Pequeños Animales (SCIVAC).
Giordana Zanna
La Dra. Giordana Zanna es licenciada en Veterinaria por la Universidad de Bari (Italia) desde el año 2000. Tras un tiempo trabajando en Italia en diversas clínicas generalistas y haciendo prácticas en la Universidad de Liverpool y la Universidad de Bristol (Reino Unido), decidió empezar la residencia en dermatología veterinaria en la Universitat Autònoma de Barcelona (UAB, España), gracias a la cual se convirtió en 2010 en diplomada europea por el Colegio Europeo de Dermatología Veterinaria. En esta misma universidad completó sus estudios de doctorado, con una tesis sobre la patogenia de la mucinosis-hialuronosis del Shar Pei, que defendió en 2010. Asimismo, es vicepresidenta de la SIDEV y secretaria de la SCIVAC, además de directora y mentora científica de dermatología. En la actualidad, Giordana trabaja en el Instituto Veterinario de Novara (Italia) como especialista en dermatología veterinaria e imparte con frecuencia diversos cursos nacionales, tanto en Italia como en España, así como conferencias en congresos internacionales. Es autora de varios artículos publicados en revistas nacionales e internacionales y sigue disfrutando de su faceta investigadora, especialmente en lo que respecta a técnicas de diagnóstico no invasivas, como la dermoscopia.